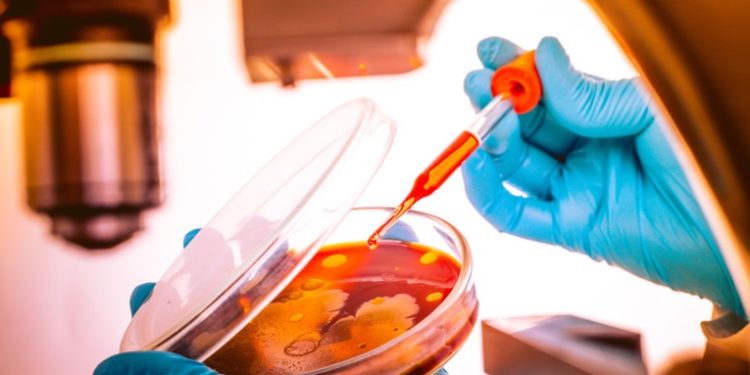

2022-08-24
Nuevo Mundo – 96.1
Una nueva cepa recombinante del virus del VIH-1, que provoca el desarrollo del sida, ha sido descubierta en Chipre, informó este martes Philenews.De acuerdo con los científicos de la Universidad de Chipre y del Laboratorio Nacional del VIH de Los Álamos, en el estado de Nuevo México (EE.UU.), el genoma de la nueva cepa, denominada CRF91_cpx, es una combinación de cuatro ya conocidas del VIH-1: CRF02_AG, G, J y U.Además, el análisis epidemiológico muestra que actualmente la cepa circula principalmente entre hombres homosexuales chipriotas, y ya se han detectado 14 casos. Según los datos, la CRF91_cpx sigue transmitiéndose en Chipre con síntomas clínicos actualmente desconocidos.Los resultados del descubrimiento han sido publicados en la revista médica internacional Virulence.
Una nueva cepa recombinante del virus del VIH-1, que provoca el desarrollo del sida, ha sido descubierta en Chipre, informó este martes Philenews.
De acuerdo con los científicos de la Universidad de Chipre y del Laboratorio Nacional del VIH de Los Álamos, en el estado de Nuevo México (EE.UU.), el genoma de la nueva cepa, denominada CRF91_cpx, es una combinación de cuatro ya conocidas del VIH-1: CRF02_AG, G, J y U.
Además, el análisis epidemiológico muestra que actualmente la cepa circula principalmente entre hombres homosexuales chipriotas, y ya se han detectado 14 casos. Según los datos, la CRF91_cpx sigue transmitiéndose en Chipre con síntomas clínicos actualmente desconocidos.
Los resultados del descubrimiento han sido publicados en la revista médica internacional Virulence.